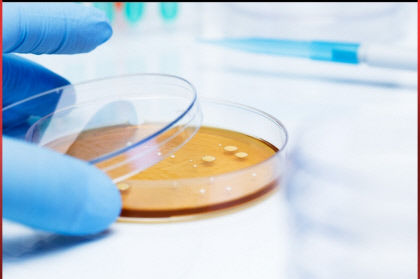
temp_1629686989008.1207087166

|
| 씨티씨생명과학 연구진이 항ASD와 항ADHD를 활용해 케피어 부스터를 개발하고 있다.씨티씨생명과학 제공 |
 |
| 씨티씨생명과학과 미국 MD 마이클 켈리 박사가 개발한 케피어 부스터.씨티씨생명과학 제공 |
씨티씨생명과학과 미국 오클랜드 출신의 MD 마이클 켈리(Michael Kelly) 박사는 대사물질인 뮤코다당(Mucopolysaccharide)과 콜린(Choline) 계열 부산물인 에멀션(Emulsion)화를 통해 항ASD(Autism Spectrum Disorder:자폐성범주장애)와 항ADHD(Attention Deficit Hyperactivity Disorder:과다행동장애) 물질로 개발한 ‘케피어 부스터(Kefir Booster)’를 출시한다고 24일 밝혔다.
이 회사는 이직까지 명확한 ASD 치료제가 개발되지 않은 상황에서 출시하는 케피어 부스터는 해당 질환별 보조 치유 기능을 갖춘 제품으로 신속한 상용화를 거쳐 조만간 보급에 나설 방침이다.
마이크로바이옴 배양 및 발효 기술을 접목한 씨티씨생명과학의 케피어 부스터는 세계적 미생물 분야 석학으로 이탈리아 출신 마르코 루지에로(Marco Ruggiero) 박사와 디트리히 클링하르트(Dietrich Klinghart) 박사의 ‘R-K 프로토콜(Tailoring the Ruggiero-Klinghardt Protocol to Immunotherapy of Autism. Antonucci N, Klinghardt D, Pacini S, Ruggiero M. 24 Apr 2019, American Journal of Immunology, Vol. 14, pages 34-41)’을 기초로 개발한 미생물 과학의 혁신 개발 제품이라는 평가를 받는 것으로 알려졌다.
현재 씨티씨생명과학은 루지에로 박사팀과 함께 지난달 비대면 화상 아카데미를 통해 발표한 국내 미생물 공동연구소 건립을 준비하고 있으며, 대구·경북지역 유명 대학과 산학 협력을 추진하고 있다.
씨티씨생명과학 관계자는 "케피어 부스터는 전 세계 의학지와 저널에 10회 이상 게재될 정도의 신기술 제품으로 미국 현지에서 수차례 임상 실험을 거쳤다"라면서 "향후 영업력을 갖춘 법인과 판매 계약을 통해 하반기에 출시할 케피어 포르테, 케피어 노바 시리즈 등 케피어 부스터 관련 제품 공급을 계기로 대구 ·경북대학과 협력을 강화할 것"이라고 밝혔다.
백종현기자 baekjh@yeongnam.com

백종현
영남일보(www.yeongnam.com), 무단전재 및 수집, 재배포금지




